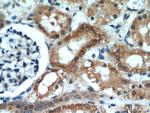
BCS1L Antibody in Immunohistochemistry (Paraffin) (IHC (P))

Search
Proteintech
BCS1L Polyclonal Antibody
{{$productOrderCtrl.translations['antibody.pdp.commerceCard.promotion.promotions']}}
{{$productOrderCtrl.translations['antibody.pdp.commerceCard.promotion.viewpromo']}}
{{$productOrderCtrl.translations['antibody.pdp.commerceCard.promotion.promocode']}}: {{promo.promoCode}} {{promo.promoTitle}} {{promo.promoDescription}}. {{$productOrderCtrl.translations['antibody.pdp.commerceCard.promotion.learnmore']}}
产品信息
10175-2-AP
已发表种属
宿主/亚型
分类
类型
抗原
偶联物
形式
浓度
保存条件
运输条件
靶标信息
This gene encodes a homolog of the S. cerevisiae bcs1 protein which is involved in the assembly of complex III of the mitochondrial respiratory chain. The encoded protein does not contain a mitochondrial targeting sequence but experimental studies confirm that it is imported into mitochondria. Mutations in this gene are associated with mitochondrial complex III deficiency and the GRACILE syndrome. Five alternatively spliced transcripts encoding the same protein have been described.
仅用于科研。不用于诊断过程。未经明确授权不得转售。